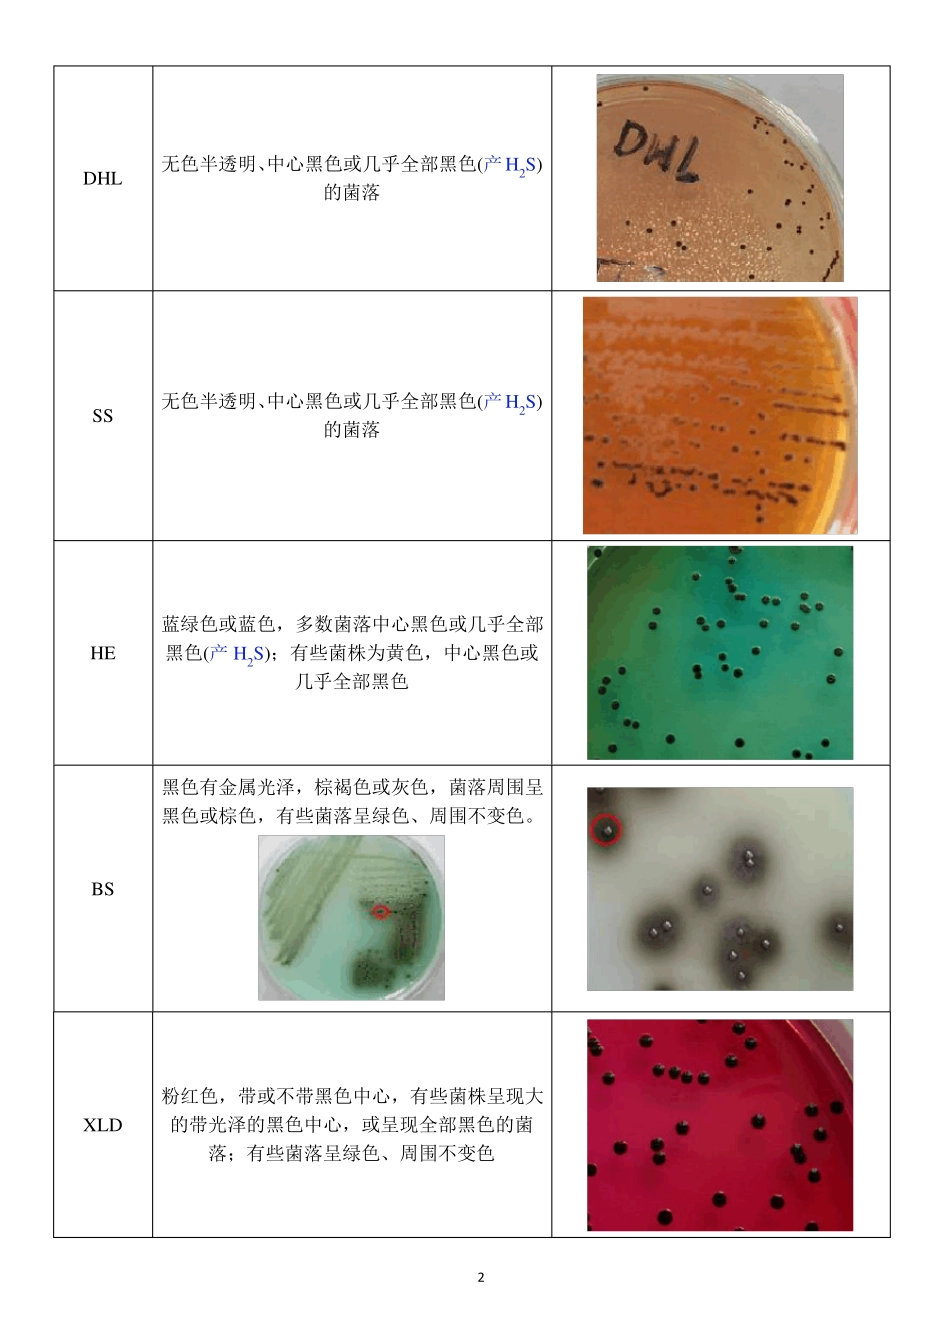
肠道病原菌——沙门氏菌属_第2页

第一章沙门氏菌属一、分类属沙门菌属域细菌域门变形菌门纲Y-变形菌纲目肠杆菌目科肠杆菌科沙门菌属主要包括肠道沙门氏菌和邦戈沙门氏菌
肠道沙门氏菌广泛存在于猪、牛、羊、家禽、鸟类、鼠类等多种动物的肠道和内脏中
根据沙门氏菌的致病范围,可将其分为三大类群
类群第一类群第二类群第三类群致病范围只对人致病类型伤寒沙门氏菌、副伤寒沙门氏菌(甲型、乙型、丙型)、仙台沙门氏菌肠炎沙门氏菌、纽波特沙门氏菌等食物中毒沙门氏菌群(对人猪霍乱沙门氏菌(最强)、鼠伤寒沙门氏菌(首位)、和动物均致病)马流产沙门氏菌、鸡白痢沙门氏菌、猪霍乱沙门氏菌、对动物致病(很少感染人)鼠伤寒沙门氏菌二、生物学特征1
形态染色特性G-无芽孢杆菌
大小通常为0
0μm,菌端钝圆,散在,偶有短丝状,无荚膜(除鸡白痢沙门氏菌和鸡伤寒沙门氏菌外),一般均有周身鞭毛,能运动,绝大多数菌株有菌毛
培养特性需氧或兼性厌氧菌;生长温度范围为10~42℃,最适生长温度为35~37℃;适宜pH为6
8;对营养要求不高,在普通培养基中生长旺盛;胆盐可促进其生长
培养基NA菌落特征备注圆形、光滑、湿润、无色半透明、边缘整齐或鸡白痢、鸡伤寒、猪副伤寒、甲型副伤不太整齐的中等大小(2~4mm)菌落寒沙门氏菌等只能长成细小菌落MAC无色透明或半透明(不发酵乳糖)、中等大小、边缘整齐、光滑、稍微隆起EMB无色透明或半透明(不发酵乳糖)、中等大小、边缘整齐、光滑、稍微隆起1DHL无色半透明、中心黑色或几乎全部黑色(产H2S)的菌落SS无色半透明、中心黑色或几乎全部黑色(产H2S)的菌落HE蓝绿色或蓝色,多数菌落中心黑色或几乎全部黑色(产H2S);有些菌株为黄色,中心黑色或几乎全部黑色黑色有金属光泽,棕褐色或灰色,菌落周围呈黑色或棕色,有些菌落呈绿色、周围不变色
BSXLD粉红色,带或不带黑色中心,有些菌株呈现大